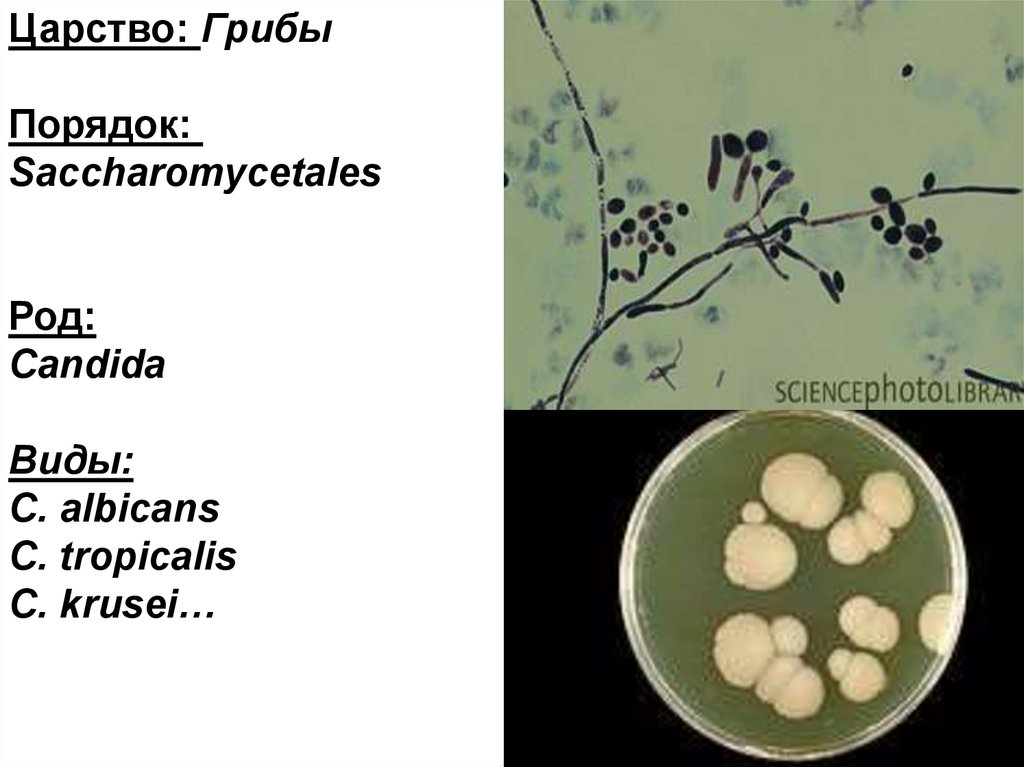

Similar presentations:
Микрофлора организма человека. Основы инфектологии
1.
Микрофлора организмачеловека.
Основы инфектологии.
2.
ЭКОЛОГИЯМИКРОРГАНИЗМОВ
3.
4.
ЭКОЛОГИЯ МИКРООРГАНИЗМОВ – наука,изучающая взаимосвязи между микроорганизмами в
условиях среды их обитания.
ЭКОСИСТЕМА - биологическая система, состоящая из
сообщества живых организмов (биоценоз), среды их
обитания (биотоп), системы связей, осуществляющей
обмен веществом и энергией между ними.
НОРМАЛЬНАЯ МИКРОФЛОРА – естественная
совокупность микробных популяций, наиболее часто
выделяемых из организма здорового человека,
колонизирующих различные биотопы и не
причиняющих ему видимого вреда
5.
МИКРОБИОЦЕНОЗ- совокупностьмикроорганизмов, населяющих
территорию с одинаковыми условиями
существования.
БИОТОП — относительно однородный по
абиотическим факторам среды участок,
заселённый живыми организмам
CИМБИОЗ –взаимодействие и
сосуществование представителей разных
биологических видов
6.
Типы симбиоза междумикро- и макроорганизмом:
КОММЕНСАЛИЗМ
МУТУАЛИЗМ
ПАРАЗИТИЗМ
7.
Типы симбиозамежду микроорганизмами
САТЕЛЛИЗМ
СИНЕРГИЗМ
НЕЙТРАЛИЗМ
МЕТАБИОЗ
АНТАГОНИЗМ
8.
Семейство: MicrococcaceaeРод:
Staphylococcus
Виды:
S. aureus
S. epidermidis
S. hominis
S. saprophyticus …
9.
Семейство:Streptococcaceae
Род:
Streptococcus
Виды:
S. mitis
S. mutans…
10.
Семейство:Lactobacillaceae
Род:
Lactobacillus
Виды:
L. acidophilus
L. сasei
L. salivarius
11.
Семейство:Corynebacteriaceae
Род:
Corynebacterium
Виды:
С.
рseudodiphtheriae
С. ulcerans
12.
Семейство:Neisseriaceae
Род:
Neisseria
Виды:
N. sicca
N. flava,
N. perflava
13.
Царство: ГрибыПорядок:
Saccharomycetales
Род:
Candida
Виды:
C. albicans
C. tropicalis
C. krusei…
14.
Семейство:Bifidobacteriaceae
Род:
Bifidobacterium
Виды:
B. animalis
B. bifidum
B. longum…
15.
Семейство:Enterobacteriaceae
Род:
Escherichia
Вид:
E. coli
16.
Протокол. Микрофлора организма человекаИсследуемый материал
1) Мазок-препарат из культуры
Streptococcus sрр.,
окраска по Граму
2) Мазок –препарат из культуры
Lactobacillus sрр,
окраска по Граму
3) Мазок- препарат из культуры
Candida spp., окраска
метиленовым синим
Что сделать
Результат
1) Изучить
морфологию
(демонстрация),
зарисовать.
1)
2) Изучить
морфологию
(демонстрация),
зарисовать.
2)
3) Приготовить мазокпрепарат,
окрасить по методу
Грама,
изучить морфологию,
зарисовать
3)
17.
ИНФЕКЦИЯ –СОВОКУПНОСТЬ ФИЗИОЛОГИЧЕСКИХ(АДАПТАЦИОННЫХ)
И ПАТОЛОГИЧЕСКИХ ПРОЦЕССОВ,
РАЗВИВАЮЩИХСЯ В МАКРООРГАНИЗМЕ
В РЕЗУЛЬТАТЕ ВЗАИМОДЕЙСТВИЯ
С МИКРООРГАНИЗМОМ
СЛЕДСТВИЕ
Инфекционный процесс –
антагонистическое взаимодействие
между микроорганизмом и макроорганизмом
в условиях окружающей среды
18. ИСХОДЫ ИНФЕКЦИИ
АБОРТИВНАЯИНФЕКЦИЯ
ЛАТЕНТНАЯ
ИНФЕКЦИЯ
ИНФЕКЦИОННОЕ
ЗАБОЛЕВАНИЕ
КРАЙНЕЕ ПРОЯВЛЕНИЕ
ИНФЕКЦИИ
С ЯРКО ВЫРАЖЕННЫМИ
АНТАГОНИСТИЧЕСКИМИ
ВЗАИМООТНОШЕНИЯМИ
19.
ОБЛИГАТНОПАТОГЕННЫЙУСЛОВНОПАТОГЕННЫЙ
ДОЗА
ВОЗБУДИТЕЛЯ
ВОЗБУДИТЕЛЬ
УСЛОВИЯ РАЗВИТИЯ
ИНФЕКЦИОННОГО
ЗАБОЛЕВАНИЯ
ЗАЩИТНЫЕ
СИЛЫ
ОРГАНИЗМА
ВНЕШНИЕ И
СОЦИАЛЬНЫЕ ФАКТОРЫ
20.
АДГЕЗИЯ,КОЛОНИЗАЦИЯ
ИНВАЗИВНОСТЬ,
АГРЕССИВНОСТЬ
ПАТОГЕННОСТЬ
ПРОТИВОДЕЙСТВИЕ
ЗАЩИТНЫМ
СИЛАМ
МАКРООРГАНИЗМА
ПОВРЕЖДАЮЩЕЕ
ДЕЙСТВИЕ НА
ОРГАНЫ И
СИСТЕМЫ
21.
ЭЛЕМЕНТЫ ЭПИДЕМИЧЕСКОГОПРОЦЕССА
Эпидемический процесс возникает и
поддерживается непрерывностью
взаимодействия трех основных
звеньев:
1. Источник возбудителя инфекции
2. Механизм передачи.
3. Восприимчивый организм
(население)
22.
Виды механизмов передачиВертикальный
Горизонтальные
Фекальнооральный
Контактный
Трансмиссивн
ый
Аэрозольны
й
23.
ВЕРТИКАЛЬНЫЙ МЕХАНИЗМПЕРЕДАЧИ
- передача возбудителя
инфекции от матери к
плоду на протяжении
всего периода от зачатия
до родов
24.
Источникинфекции
Восприимчивый
организм
Контактнобытовой
Пищевой
Водный
Вода,
овощи,
фрукты,
мухи,
руки
Факторы
передачи
Фекалии рвотные
массы
Пути передачи
Фекально-оральный механизм передачи
25.
Восприимчивыйорганизм
Источник
инфекции
Воздушнокапельный
(пылевой)
Контактнобытовой
Пути передачи
Выдыхаемый
воздух, пыль
Бытовые
предметы,
игрушки, руки
Факторы передачи
Аэрозольный механизм передачи
26.
Источникинфекции
Восприимчивый
организм
Заражение
переносчика
от
источника
инфекции
Комары,
мухи,
вши,
блохи,
клопы
Факторы
передачи
Путь передачи трансмиссивный, происходит
специфический перенос
возбудителя переносчиком
Трансмиссивный механизм передачи
27.
Восприимчивыйорганизм
Источник
инфекции
Прямой путь
Половой
Артифициальный
Непрямые пути
Бытовой
Раневой
Контактный механизм передачи
28.
лептоспирозБиологический
тупик
ЭПИДЕМИЧЕСКИЙ ПРОЦЕСС ПРИ
ЗООНОЗАХ
29.
Эпидемический процесс при сапронозахРезервуар – внешняя среда
(водные сапронозы –легионеллез, холера;
почвенные - подкожные микозы, газовая
гангрена).
Вода, почва
Субстрат для
накопления
возбудителя
(овощи, вода,
конденсат)
ТУПИК
Больной
человек
30. Биоплёнка-
Биоплёнкамикробное сообщество, состоящееиз клеток, плотно прикрепленных
к субстрату, поверхности или друг
к другу, заключенных в матрицу
внеклеточных полимерных
субстанций.
31. Стадии образования биопленки
• Адгезия• Колонизация
• Созревание
• Дисперсия
32.
Развитие биопленки33.
ГИАЛУРОНИДАЗАНЕЙРАМИНИДАЗА
ПЛАЗМОКОАГУЛАЗА
ФИБРИНОЛИЗИН
КОЛЛАГЕНАЗА
ЛЕЦИТИНАЗА
ФЕРМЕНТЫ АГРЕССИИ
ИНВАЗИВНОСТЬ,
АГРЕССИВНОСТЬ
ПРОТИВОДЕЙСТВИЕ
ЗАЩИТНЫМ СИЛАМ
МАКРООРГАНИЗМА
КАПСУЛА
А-ПРОТЕИН
СТАФИЛОКОККА
М-ПРОТЕИН
СТРЕПТОКОККА
Vi-АНТИГЕН
БРЮШНОТИФОЗНОЙ
ПАЛОЧКИ
34. СРАВНИТЕЛЬНАЯ ХАРАКТЕРИСТИКА ТОКСИНОВ
СВОЙСТВАТОКСИНЫ
ЭКЗОТОКСИНЫ
ЭНДОТОКСИНЫ
ХИМИЧЕСКАЯ
ПРИРОДА
БЕЛКИ
ЛИПОПОЛИСАХАРИДЫ
ВЫДЕЛЯЮТСЯ ИЗ
ЖИВОЙ КЛЕТКИ
+
—
ТОКСИЧНОСТЬ
ВЫСОКАЯ
МЕНЕЕ ТОКСИЧНЫ
ИЗБИРАТЕЛЬНОСТЬ
ДЕЙСТВИЯ
ВЫСОКАЯ
НИЗКАЯ
ТЕРМОЛАБИЛЬНЫ
ТЕРМОСТАБИЛЬНЫ
ОБЕЗВРЕЖИВЕТ
ОБЕЗВРЕЖИВАЕТ
ЧАСТИЧНО
ВЫСОКАЯ
СЛАБАЯ
ГРАМ +
ГРАМ −
ГРАМ −
ДЕЙСТВИЕ
ТЕМПЕРАТУРЫ
ДЕЙСТВИЕ
ФОРМАЛЬДЕГИДА
АНТИГЕННОСТЬ
ПРИСУТСТВУЮТ У
БАКТЕРИЙ
35. КЛАССИФИКАЦИЯ ОСНОВНЫХ ЭКЗОТОКСИНОВ
ТИПМЕХАНИЗМ
ДЕЙСТВИЯ
ПРОДУЦЕНТЫ
ЦИТОТОКСИНЫ
БЛОКИРУЮТ СИНТЕЗ
БЕЛКА
МЕМБРАНОТОКСИНЫ
ПОВЫШАЮТ
ПРОНИЦАЕМОСТЬ
МЕМБРАН
ЭРИТРОЦИТОВ,
ЛЕЙКОЦИТОВ
C. diphteriae
S. aureus
S. flexneri
S. aureus
P. aerugenosa
C. tetani
ФУНКЦИОНАЛЬНЫЕ
БЛОКАТОРЫ
(нейротоксины)
БЛОКИРУЮТ
ПЕРЕДАЧУ
НЕРВНЫХ
ИМПУЛЬСОВ В
СИНАПСАХ (В
КЛЕТКАХ
СПИННОГО И
ГОЛОВНОГО МОЗГА)
C. tetani
C. botulinum
36. КЛАССИФИКАЦИЯ ОСНОВНЫХ ЭКЗОТОКСИНОВ
ТИПТЕРМОСТАБИЛЬНЫЕ И
ТЕРМОЛАБИЛЬНЫЕ
ЭНТЕРОТОКСИНЫ
ЭКСФОЛИАТИНЫ
МЕХАНИЗМ
ДЕЙСТВИЯ
АКТИВИЗИРУЮТ
КЛЕТОЧНУЮ
АДЕНИЛАТЦИКЛАЗУ –
НАРУШЕНИЕ
ЭНТЕРОСОРБЦИИ И
РАЗВИТИЕ
ДИАРЕЙНОГО
СИНДРОМА
НАРУШАЮТ
МЕЖКЛЕТОЧНОЕ
ВЗАИМОДЕЙСТВИЕ
ПРОДУЦЕНТЫ
E. coli
S. enteritidis
V. cholerae
S. aureus
S. pyogenes
37.
Нозоареал (ареал болезни)- совокупность территорий земного шара, в
пределах которых происходит постоянное
воспроизведение заболевания.
Нозоареал глобальный – повсеместное
(убиквитарное) распространение.
Спорадическая заболеваемость –
регистрируемые заболевания единичны,
разрозненны, случаи болезни не имеют между
собой эпидемиологических связей,
заболеваемость не связана с единым
источником инфекции или заболевания не
имеют общих факторов передачи возбудителя.
38.
Экзотические (завозные) инфекции инфекционные (паразитарные) болезни, несвойственные данной местности в связи с
отсутствием в ней природных или социальных
условий, необходимых для поддержания
эпидемического процесса.
Эндемические (эндемичные) инфекции инфекционные (паразитарные) болезни,
свойственные данной местности в связи с
наличием в ней природных или социальных
условий, необходимых для поддержания
эпидемического процесса.
39.
Эпидемическая вспышка –одновременное возникновением у людей на
данной территории (в определенном коллективе)
инфекционных заболеваний, связанных одним
источником инфекции или путями ее передачи.
Эпидемия –
массовое поражение населения инфекционной
болезнью на обширной или ограниченной
территории, на которой наблюдаются
эпидемические вспышки или групповые
заболевания (семейные, школьные,
производственные и др.), связанные между
собой.
40.
Пандемия- эпидемия, распространенная в
ряде стран, на континенте, или
нескольких континентах.
Эпизоотия
- массовое поражение животных
инфекционной болезнью,
значительно превышающее
обычный уровень заболеваемости
на данной территории.

medicine
medicine








